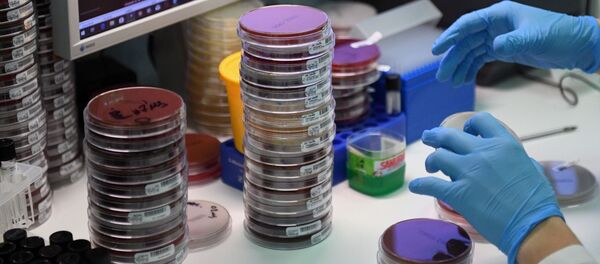
Laboratorija - Sputnik Srbija

„Tamni internet“, ilegalni deo svetske mreže, kojem se pristupa posebnim pretraživačima, do sada je bio baza za kupovinu droge, oružja, pa čak i naručivanje ubistava. Sada, u vreme pandemije virusa korona, postao je mesto gde se može kupiti krv ljudi koji su preboleli kovid-19 i koja u sebi ima zaštitna antitela protiv zaraze, prenose brojni svetski mediji.
Kako se pretpostavlja, kupci nabavljaju krv sa antitelima da bi dobili transfuziju i tako se zaštitili od infekcije novim virusom korona ili kako bi se lečili ako su već zaraženi.
Neki od sajtova dark veba zabranili su prodaju krvi, budući da postoji velika mogućnost prevare, a ilegalno tržište ne želi da na taj način naruši svoju „reputaciju“. Prodaja krvi je sada na univerzalnoj listi „zabranjene robe“ na većem delu dark veba, na kojoj su još i naručivanje ubistava, prodaja ljudskih organa i „snaf“ filmovi (filmovi u kojima se prikazuju scene pravih ubistava ili mučenja).
Međutim, kao i svako drugo tržište, i ovo ilegalno, zaštićeno jakim kriptografskim softverom, ima svoje izuzetke, pa je tako na njemu ipak moguće kupiti krv, kao i druge zabranjene stvari.
Ovim pitanjem bavila se i australijska vlada, čiji je Institut za kriminologiju uradio studiju o ilegalnoj prodaji proizvoda u vezi sa kovidom-19. I oni su otkrili ponude za prodaju krvi sa antitelima, navedene kao „pasivna imunizacija“, rekao je australijskom „Ej-Bi-Si njuzu“ Rod Brodharst, jedan od autora studije.
Kako je utvrđeno, u 12 kriptoprodavnica otkriveno je 645 ponuda za prodaju proizvoda u vezi sa kovidom-19, najviše zaštitne opreme, ali nuđeni su i lekovi, „vakcine“, testovi, čak i jedan respirator...
I programi specijalizovanih firmi za bezbednost na internetu otkrili su ponude za prodaju krvi sa antitelima.
Poreklo krvi nije poznato, ali je za neke kriptoprodavnice na kojima je ponuđena otkriveno da su registrovane u Švedskoj.
Pročitajte još: